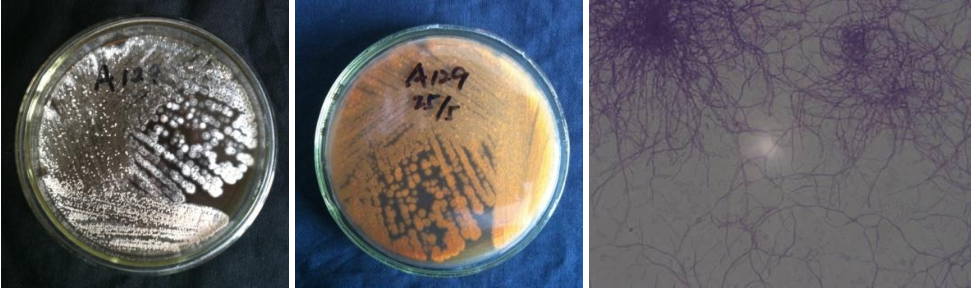

Loading...
| StrainNO | A129 |
| Classification | Streptomyces |
| 16s rDNA sequence | TTGCTTAACACATGCAAGTCGAACGATGAACCTCCTTCGGGAGGGGATTAGTGGCGAACGGGTGAGTAACACGTGGGCAATCTG CCCTGCACTCTGGGACAAGCCCTGGAAACGGGGTCTAATACCGGATACAACCACTGGGGGCATCCTCTGGTGGTGGAAAGCTCC GGCGGTGCAGGATGAGCCCGCGGCCTATCAGCTAGTTGGTGAGGTAACGGCTCACCAAGGCGACGACGGGTAGCCGGCCTGAGA GGGCGACCGGCCACACTGGGACTGAGACACGGCCCAGACTCCTACGGGAGGCAGCAGTGGGGAATATTGCACAATGGGCGAAAG CCTGATGCAGCGACGCCGCGTGAGGGATGACGGCCTTCGGGTTGTAAACCTCTTTCAGCAGGGAAGAAGCGAAAGTGACGGTAC CTGCAGAAGAAGCGCCGGCTAACTACGTGCCAGCAGCCGCGGTAATACGTAGGGCGCAAGCGTTGTCCGGAATTATTGGGCGTA AAGAGCTCGTAGGCGGCTTGTCACGTCGGTTGTGAAAGCCCGGGGCTTAACCCCGGGTCTGCAGTCGATACGGGCAGGCTAGAG TTCGGTAGGGGAGATCGGAATTCCTGGTGTAGCGGTGAAATGCGCAGATATCAGGAGGAACACCGGTGGCGAAGGCGGATCTCT GGGCCGATACTGACGCTGAGGAGCGAAAGCGTGGGGAGCGAACAGGATTAGATACCCTGGTAGTCCACGCCGTAAACGGTGGGC ACTAGGTGTGGGCAACATTCCACGTTGTCCGTGCCGCAGCTAACGCATTAAGTGCCCCGCCTGGGGAGTACGGCCGCAAGGCTA AAACTCAAAGGAATTGACGGGGGCCCGCACAAGCGGCGGAGCATGTGGCTTAATTCGACGCAACGCGAAGAACCTTACCAAGGC TTGACATACACCGGAAACATCCAGAGATGGGTGCCCCCTTGTGGTCGGTGTACAGGTGGTGCATGGCTGTCGTCAGCTCGTGTC GTGAGATGTTGGGTTAAGTCCCGCAACGAGCGCAACCCTTGTCCCGTGTTGCCAGCAGGCCCTTGTGGTGCTGGGGACTCACGG GAGACCGCCGGGGTCAACTCGGAGGAAGGTGGGGACGACGTCAAGTCATCATGCCCCTTATGTCTTGGGCTGCACACGTGCTAC AATGGCCGGTACAATGAGCTGCGATACCGCGAGGTGGAGCGAATCTCAAAAAGCCGGTCTCAGTTCGGATTGGGGTCTGCAACT CGACCCCATGAAGTCGGAGTCGCTAGTAATCGCAGATCAGCATTGCTGCGGTGAATACGTTCCCGGGCCTTGTACACACCGCCC GTCACGTCACGAAAGTCGGTAACACCCGAAGCCGGTGGCCCAACCCCTTGTGGGAGGGAGCTGTCGAAGGTGGGACTGGCGATT GGGACGAGGTCGTAACCCTTGA |
| Strain Morphology Photos | |
| Morphological Description | hyphae branch;apart;mycelium thick and short;old filament broken into a barrel;top of the air filament swells into a spindle |